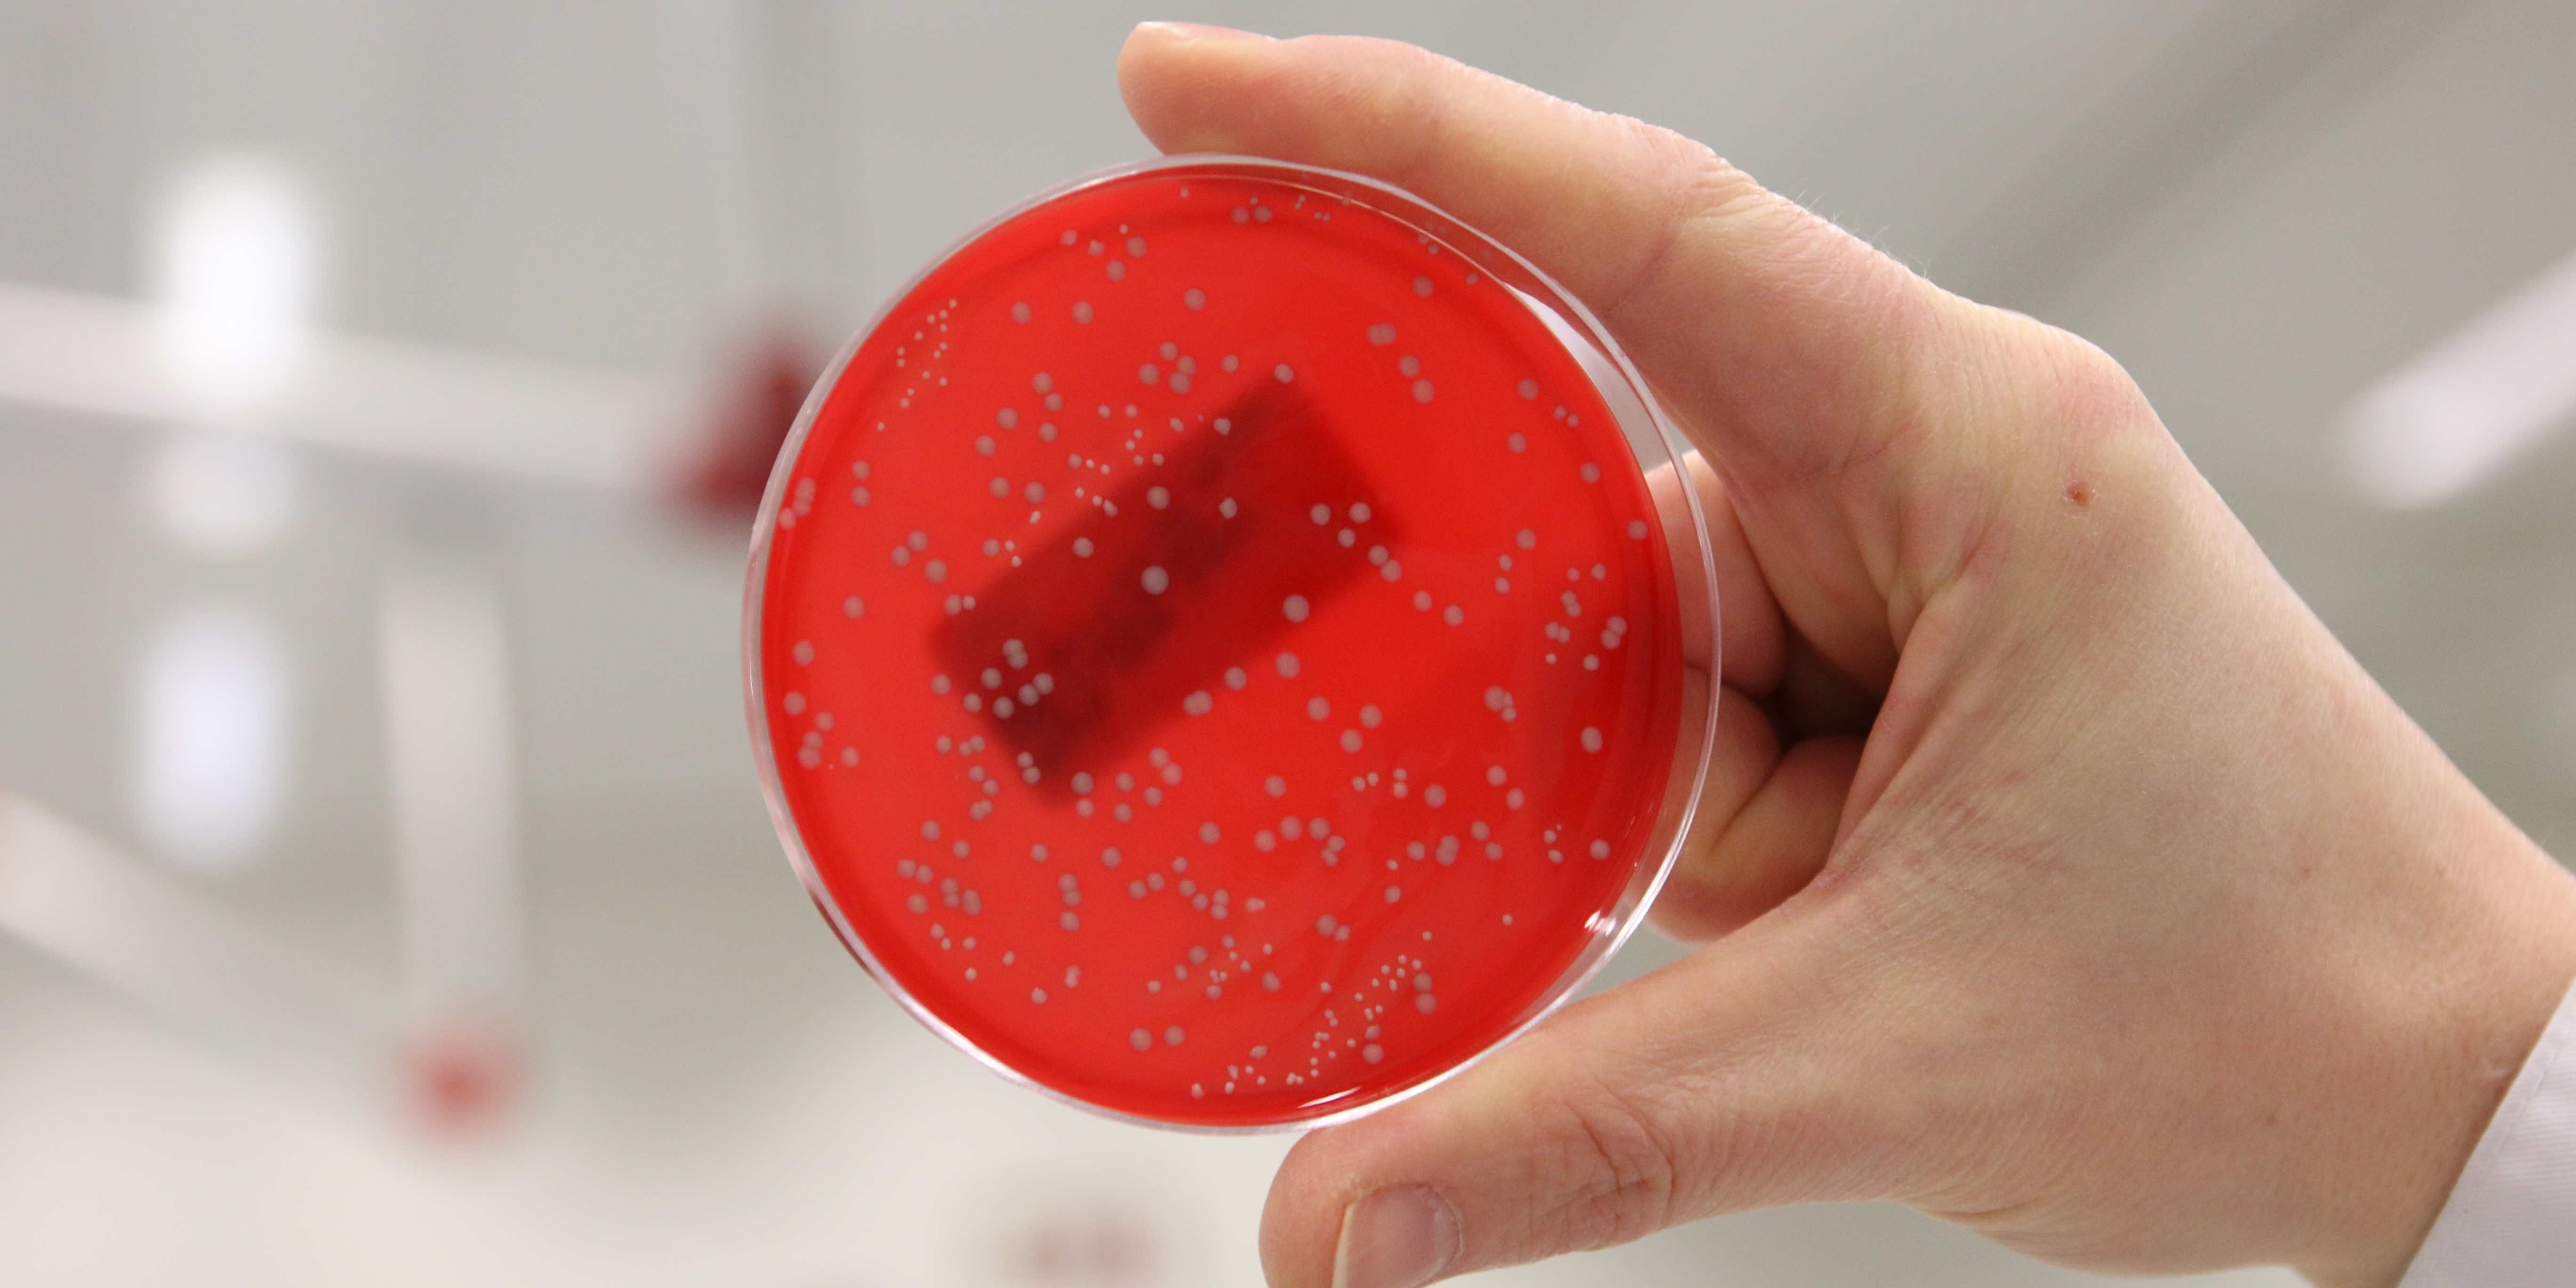

- Home
- Organisation
Our organisation
GD Group has the ambition is to be a valuable partner for animal health, both now and in the years to come. Besides farm animals, the Group’s companies also focus on hobby animals, companion animals and horses, and also examines human and plant samples.
We are working towards a healthily expanding and efficient organisation. Besides growing our operations in the Netherlands , we also see opportunities for further international growth. The Group already has subsidiaries in Belgium, Germany, Austria, Norway, US and Ireland. Organisational structure
In 2024 GD Group achieved a consolidated turnover of 66 million and has around 500 employees.
Our vision
The GD Group is driven by a passion to improve animal health and welfare. We aims to be a leading family of companies that provides insight into animal health through dedication, innovation and continuous improvement of its performance. GD Group companies operate to high standards and strive for efficiency and synergy.

Our mission
The mission of the GD Group is providing insight into animal health by obtaining data, transforming data into information and using this information to provide actionable items and practical applications for animal owners and society.
Our values




